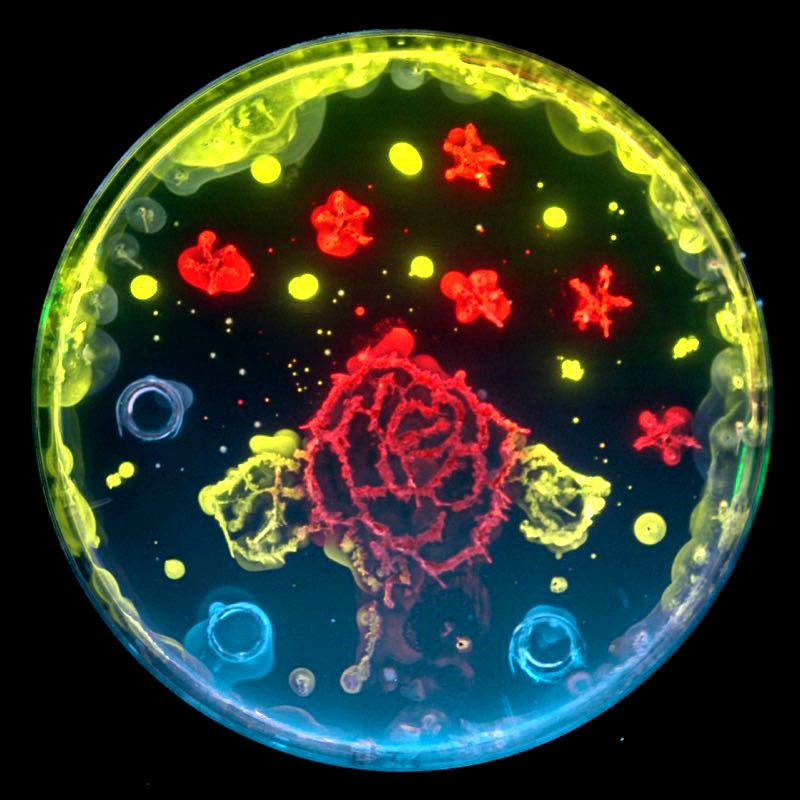
Misono_Lab's tweet image. Just found an old pic of a drawing by a high schooler with some fluorescent proteins. Nothing scientific, so I will not submit it to the ASCB GFP image contest. Anyway, happy 25th years of GFP! #GFP #greenfluorescentprotein

Miso 🧪 Neurobiology
@Misono_Lab
Neurobiologist 🧠 #cellbiology 🔬 #neurobiology 🧬 #neuroscience 🥼 http://researchgate.net/profile/Hiroak…
You might like
Tau lacking the microtubule-binding domain/repeats diffuses almost freely and can still localize to the axon.... #neuroscience #CellBiology

Motor cortex can directly drive the globus pallidus neurons in a projection neuron type- dependent manner in the rat doi.org/10.7554/eLife.…
Survivor bias at its finest, with bonus guilt. I'm sure such letters fill the drawers of people that had to quit science, not because they did not believe enough in themselves
This is the rejection letter for the work that just won the Nobel Prize. Believe in yourself. Everyone else will catch up eventually.

A comprehensive review: current knowledge and open questions about axonal transport, by @PGuedes_Dias and @ErikaHolzbaur science.sciencemag.org/content/366/64…

#EESImaging @EMBLEvents Now Harald Hess blows our minds with their cryo SIM/PALM and FIB SEM imaging. Optical imaging at ~8K to exploit exotic photo-physics and FIB SEM for 3D ultrastructure. Heroic efforts by the team at Janelia and collaborators! biorxiv.org/content/10.110…

Undergrad game me this bag based on the cover image of our recent paper!

Going to #SGPSOBLA2019 @SOBLA_BIOF? Check out our studies on human KCNMA1 mutations from @HansMoldenhauer (poster 45 Thursday)
#Neurologists & patients interested in Kamiyah’s story from @Netflix @NYTMag series #Diagnosis can find more information about KCNMA1-linked channelopathy in this review article by Andrea L Meredith (@BKChannels of @UMmedschool) et al.: bit.ly/2HerNJA

Neuronal axons undergo transient deformation during large cargo transport. Preprint from @TongIrisWang1 et. al. biorxiv.org/content/10.110… Live cell SIM movies with our probe SiR-actin on @zeiss_micro ELYRA are just wow: look at those actin stripes deforming! spirochrome.com/product/sir-ac…
Just found an old pic of a drawing by a high schooler with some fluorescent proteins. Nothing scientific, so I will not submit it to the ASCB GFP image contest. Anyway, happy 25th years of GFP! #GFP #greenfluorescentprotein
A good representation of our recent efforts to help patients with KCNMA1/BK channel mutations! (despite the overstatement at the end-- we had no control over Netflix's interpretation of the progress of our research)
Be sure to watch the Netflix program #Diagnosis tinyurl.com/yxwdat23 Our faculty member, Dr. Andrea Meredith, is featured in Episode #4 for her research into a gene mutation known as KCNMA1-linked channelopathy. The episode features children suffering from this gene mutation.
Check out this year's diverse panel of jurors for the 2019 Image of the Year #microscopy contest. Submit your best images at - bit.ly/2HtAXSC
Be sure to watch the Netflix program #Diagnosis tinyurl.com/yxwdat23 Our faculty member, Dr. Andrea Meredith, is featured in Episode #4 for her research into a gene mutation known as KCNMA1-linked channelopathy. The episode features children suffering from this gene mutation.
United States Trends
- 1. #BaddiesUSA 51K posts
- 2. Rams 27.9K posts
- 3. Cowboys 97.2K posts
- 4. Eagles 137K posts
- 5. Scotty 8,903 posts
- 6. #TROLLBOY 1,721 posts
- 7. Chip Kelly 7,878 posts
- 8. Stafford 13.7K posts
- 9. Bucs 12K posts
- 10. Baker 20.5K posts
- 11. Raiders 65.3K posts
- 12. #RHOP 10.6K posts
- 13. Stacey 29.5K posts
- 14. #ITWelcomeToDerry 13.2K posts
- 15. Teddy Bridgewater 1,158 posts
- 16. Todd Bowles 1,934 posts
- 17. Ahna 6,009 posts
- 18. Lemmy 4,397 posts
- 19. DOGE 157K posts
- 20. Vin Diesel N/A
Something went wrong.
Something went wrong.




































